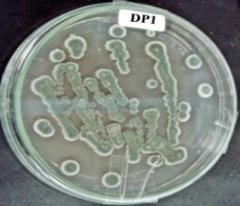
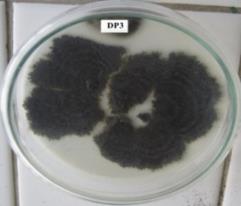
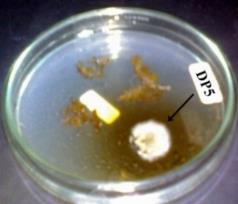
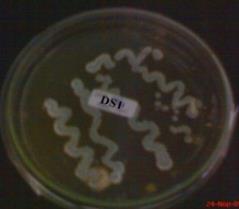
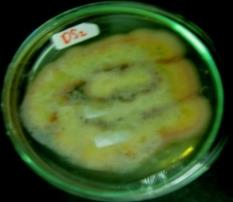

Int J Pharm Pharm Sci, Vol 7, Issue 12, 95-99Original Article
ISOLATION OF ENDOPHYTIC FUNGI FROM ARTEMISIA ANNUA, L AND IDENTIFICATION OF THEIR ANTIMICROBIAL COMPOUND USING BIOAUTOGRAPHY METHOD
Indah Purwantinia, Wahyonoa, Mustofab, Ratna Asmaha
aFaculty of Pharmacy, Gadjah Mada University, Yogyakarta, Indonesia, bFaculty of Medicine, Gadjah Mada University, Yogyakarta, Indonesia
Email: indahp@ugm.ac.id
Received: 07 Aug 2015 Revised and Accepted: 27 Oct 2015
ABSTRACT
Objective: The aims of this study were (1) to isolate endophytic fungi from A. annua, (2) to find out their activity in inhibiting microorganisms’ growth and (3) to investigate the active compound of the selected fungus.
Methods: A. annua herb was cleaned by putting it in running water and then the leaves, stems, and roots were separated. They were washed using chlorinated water, 70% ethanol, and distilled sterile water successively. Each part of the plant was cut into small pieces, grown in potato dextrose agar (PDA) medium, and incubated at room temperature. The endophytic fungi obtained were tested for their anti microorganism activity against bacteria Staphylococcus aureus, Streptococcus mutans, Salmonella typhi, Bacillus subtilis, and the fungi Malassezia furfur and Candida albicans. Identification of active compound was done using bio-autography method.
Results:This study obtained 7 endophytic fungi successfully and they were encoded IP-1, IP-2, IP-3, IP-4, IP-5, IP-6, and IP-7. All the fungi demonstrated antibacterial or antifungal activity, with IP-4 had the greatest activity. IP-4 showed septate brown hyphae, elliptical to cylindrical conidia, pale to dark brown in colony color, terminal and intercalary swellings conidiophores. Extract of endophytic fungi (IP-4) had only one antimicrobial compound indicated by the presence of clear zone at Rf value of 0.38 which could not be detected by using spray reagents.
Conclusion: Endophytic fungi were isolated successfully from the leaves of A. annua demonstrated antibacterial and antifungal activities. From 7endophytic fungi obtained, fungi encoded IP-4 had the greatest activity. It was classified into Cladosporium sp. By using bioautography method, the active compound was assumed as dimethyl cladosporine.
Keywords: Endophytic fungi, Artemisia annua, L., Antibacterial, Antifungal, Bioautography.
© 2016 The Authors. Published by Innovare Academic Sciences Pvt Ltd. This is an open access article under the CC BY license (http://creativecommons.org/licenses/by/4.0/)
INTRODUCTION
Infectious diseases affect many people in the world especially in developing countries such as Indonesia. Infection-causing microorganisms mainly bacteria, have led to the high death rate. According to World Health Organization (WHO) data, in 2004 deaths caused by diarrhea in Indonesia reached 13% in children less than 5 y old and 16.8% of deaths in the world [1]. Lately, there is an increase in microorganisms’ resistance to a wide range of antibiotic, which encourages discovery of new antibiotics. One source that can be used to discover is endophytic microbe.
Endophytic microbes are microbes that live in the plant tissue at a certain period and are able to form colonies in living plant tissues without harming their host. Each plant can contain high levels of endophytic microbes that can produce biological compounds or secondary metabolites, which are considered to be due to co-evolution or genetic transfer/recombination from the host plant into endophytic microbes [2, 3].
It is expected that endophytic microbes isolated from a medicinal plant can produce secondary metabolites in equal to or higher yield than original plant. This is very advantageous because we do not need to cut down the plant to be taken as a material for the drug, which most likely requires decades to be harvested [4]. Endophyte maybe contains the same or identical compounds as those produced by their host plant although according to Strobel and Daisy this is a rare case [5]. An example for that is taxol, a drug used for cancer treatment that is produced by Taxus brevifolia, is also produced by the endophyte isolated from this plant [6].
Most of the endophytic microbes found in plants are bacteria and fungi and every plant contains one or more endophytes [7]. Researchers discovered many new antibiotics produced by them. Dreyfuss and Chappela estimated that there were at least one million species of endophytic fungi [8]. It is known that the endophytes produce bioactive compounds, and almost 60% of them produce antibiotic [2]. There has been many successful endophytes isolation from the host plant. Many bioactive compounds can be isolated, and their chemical structures were known. Some antibiotics i.e. criyptocandin and cryptocin were produced by Cryptosporiopsisquercina, an endophytic fungi isolated from plant Tripterigeumwilfordii, which had activity as an inhibitor the growth of fungi C. albicans and Trichophyton sp. [5]. Ecomicin founded by Miller et al. is known to have antifungal activity [9]. Pseudomicin was identified by Harrison et al. [10] and produced by the endophytic fungal. In 2002, Castillo et al. stated that munumbicin, antibiotic produced by endophyte Streptomyces sp NRRL 30 562, could inhibit the growth of Bacillus subtilis and Mycobacterium tuberculose which is multiresistant to antibiotics [11]. Antibiotic kakadumicin, which has the same spectrum as munumbicin was successfully isolated [12]. The parameters in plant selection for examination are (1) the plant has been used by people to treat an illness, (2) the plant grows in an unfamiliar environment, (3) endemic plant, or (4) plant grows in an area with great biodiversity [5]. In this study, A. annua herb was selected as an object research because of its antimicrobial activity, which was supported by essential oil and derivate of dihydroartemisinin contents [13, 14].
This plant has been used traditionally and leads phase III clinical trials as an anti-malarial [14]. It is also known to have activity as an immunosuppressant [15], anti-inflammatory, analgesic, and antipyretic [14]. A. annua contains essential oils, a derivate of dihydroartemisinin [14], artemisinin, artemisinic acid, triterpenoids, phenolics, flavonoids, coumarin [16], arteannuin A, B, C and D, artemisiten, epide-oxyarteannuin, artemisinin G, annuaepoxide, annulida, norannuic acid, artemether, arteether [17]. There are previous reports on the isolation of endophytes from A. annua but there is an assumption that different environmental factors, including physical conditions and biological situations in the nature may change the behavior of microbes and favor the production of diverse range of secondary metabolites. Therefore, the current study was undertaken to isolate endophytic fungi from A. annua, which cultivated in Tawangmangu (Indonesia) and screened them for the presence of any antibacterial activity.
MATERIALS AND METHODS
Materials
A. annua plant samples were taken from Tawangmangu, media nutrient agar (NA) (Oxoid), nutrient broth (NB) (Oxoid), bacteriological agar (Oxoid), potato dextrose broth (PDB) and potato dextrose agar (PDA), Sabouroud Dextrose Broth (SDB), bacteria: Staphylococcus aureus, Streptococcus mutans, Salmonella typhi, Escherichia coli, and Bacillus subtilis, fungi: Candida albicans and Malassezia furfur, silica gel F254 for TLC, n-hexane, ethyl acetate.
Isolation of endophytic fungi from A. annua
Several samples were taken from the stems, leaves, and roots of the plant, then immediately put into sterile plastic containers. Samples of the plant were washed thoroughly under running water. The outer layer of the stems was discarded, and subsequently its surface was sterilized successively with chlorinated water, 70% alcohol, and sterile water. Each part of the plant (stems, leaves, and roots) were cut to small pieces and planted on PDA medium in petri dishes, then incubated at room temperature for 3-5 d until fungal growth was initiated. The endophytic fungi were inoculated in new medium PDA respectively to obtain pure cultures.
Antimicroorganims assay using diffusion method
The pure cultures were tested for their antimicrobial activity using the test microorganisms i.e. bacteria S. aureus, S. mutans, S. typhi, and B. subtilis, and the fungi M. furfur and C. albicans. Antimicrobial activity was examined by using diffusion method. One ose needle of each test microorganism was inoculated into medium NB for bacteria and SDB for fungi. The bacteria were incubated for 18-24 h at a temperature of 36-37 oC while the fungi were at room temperature. Bacteria and fungi suspensions were adjusted to 0.5 McFarland to achieve 1.5 x 108 CFU/ml. Approximately 100 µl of standardized bacteria and fungi suspension was transferred into 10 mL medium NA for bacteria and PDA for fungi and then poured into petri dish until solidified. Pure culture of each endophytic fungus obtained was plugged and placed into the medium above. After incubation for 18-24 h, a clear area around the endophytic fungi plug was observed and measured for its diameter. It has been noted that the greater diameter of clear area, the greater antimicroorganism activity.
Identification of endophytic fungus
The most active fungus (IP-4) was identified based on morphological characteristics, which observed using the microscopic method. Microscopic observations were made from preparations that were mounted in lactic acid.
Fermentation of endophytic fungi
The selected fungus was fermented using PDB medium and was agitated on 200 rpm, then incubated at room temperature for 14 d of fermentation. The fungal culture was separated between the cells and the fluid by centrifugation. Fluid was extracted by liquid-liquid partition using ethyl acetate. Ethyl acetate fraction was evaporated using rotary vacuum evaporator to remove the solvent until high viscosity in its consistency. This extract was used to identify the chemical properties of its antimicrobial active substance.
Bioautography technique
An amount of the extract was loaded onto TLC plate (silica gel F254) and developed using toluene: ethyl acetate: formic acid (6:3:1 v/v/v) as a mobile solvent system. The length of elution was 8 cm. Developed plate was air dried to remove traces of the solvent and applied to the antimicrobial activity. TLC plate was placed into the test medium (NA medium seeded with the tested microorganism, i.e. E. coli) allowed for 30 min, and then removed from the medium. The test medium was incubated at room temperature for 18-24 h. The zones of growth inhibition appear at the places where the antimicrobial compounds were in contact with the agar layer.
Chemical analysis
The other plates (developed with the same TLC system above) were used for chemical properties identification. Separated chemical compounds were visualized using the light of UV 254 and 366 nm, Dragendorff, FeCl3, dinitrophenylhydrazine (DNPH) and acidified anisaldehyde as spray reagents.RESULTS AND DISCUSSION
The discovery of new antibiotic from a natural source is done through a screening. Screening is a selective procedure to detect and isolate desired metabolites or microbes from a large population. Screening can be divided into two stages: primary and secondary screening. The steps in primary screening include a source selection, cultivating microbes, isolating and collecting microbes and examining the biological activity of the compounds; while in secondary screening include selecting microbial colonies, optimizing conditions for growth (temperature, pH, period of incubation, the kind of media, etc.), observing morphological and genetic characteristics, and identifying the active substances [18].
Isolation of endophytic fungi was done by cultivate the part of the plant into PDA medium which commonly used to culture the fungus. PDA is a complex medium because it contains potato infusion that is not known for certain constituent content. This medium has a composition in the form of potato infusion and glucose with a pH of 5.4±2. Fungi can grow easily on complex media with acidic and a high-carbon source.
There were seven endophytic fungi successfully isolated in this study, originated from the leaves of A. annua, and they were then encoded IP-1, IP-2, IP-3, IP-4, IP-5, IP-6 and IP-7 (fig. 1). None of the endophytic fungi was obtained from stem and root of the herb. Each fungus was characterized by observing its color, elevated, colony shape, and colony texture. Observation of fungi in this study based on the protocol to the determination of morphological characteristics by Ellis et al. was shown in fig. 1[19]. It appears that none of the endophytic fungi that had similar morphology, thus allegedly that the fungi obtained were of different genus or species. Further microscopic and molecular observations are needed to determine genus and species of fungi.
The activity of the endophytes in inhibiting microorganisms’ growth is detailed in table 1. All the fungus demonstrated antibacterial activity and only three fungi had antifungal activity especially against M. furfur. None could inhibit C. albicans growth. Three endophytic fungi (IP-1, IP-2, and IP-3) showed a broad spectrum of antibacterial activity, but the others showed a narrow spectrum. IP-1, IP-2, and IP-3 could inhibit the growth of all test bacteria. Based on diameter size of inhibition zones around the fungi plugs and their spectrums of antibacterial activity, it can be concluded that fungi encoded IP-4 had the highest activity as an antimicrobial. This result needs for further investigation because there is the lack in the method used that antibacterial activity depends on its capability to diffuse through the medium.
Microscopical or conventional method was used to determine the genus of endophytic fungi encoded IP-4. The weakness of this method is impossible to fungi that cannot produce spores on the media, so it takes the optimization of the growth of fungi in a variety of media. Many endophytic fungi produce spores unsuccessfully on the used medium to grow in the laboratory caused very hard to be identified [20, 21]. If it happens, it is necessary to initiate the formation of spores with a variety of techniques.
IP-4 showed septate brown hyphae, elliptical to cylindrical conidia, pale to dark brown in colony color, terminal, and intercalary swelling conidiophores (fig. 2). These characters make it classified into Cladosporium sp. This fungus produces antibacterial compounds such as cladosporine, methyl cladosporine, dimethyl cladosporin and mono acethylcladosporine (table 2) [22].
The TLC profile of those compounds was published by Wagman and Weinstein as shown in table 2 [23]. Identification of active compound was performed using contact bioautography method. This method is similar to the one used in agar diffusion methods. The difference is that the tested compounds diffuse to inoculated agar medium from the chromatographic plate. The clear zone in the medium indicates the presence of antimicrobial compound. In this research, TLC plate was developed using toluene: ethyl acetate: formic acid (6:3:1 v/v) as mobile phase that similar to that used by Wagman and Weinstein [23]. The result showed that extract of endophytic fungi (IP-4) had only one antimicrobial compound indicated by the presence of one clear zone at Rf value of 0.38 (fig. 3). Based on data in table 2, the possible active compound in this extract was dimethyl cladosporine.
|
 |
|
IP-1 Colony pigmentation:bluish green Colony shape:entire edge Texture:spongy. Elevation:growth into medium |
IP-2 Colony pigmentation:brownish green Colony shape:fimbriate Texture:dry. Elevation:flate |
IP-3 Colony pigmentation:black Colony shape:lobate Texture:furry Elevation:raised |
 |
|
|
IP-4 Colony pigmentation:black Colony shape:entire edge Texture:woolly. Elevation:convex |
IP-5 Colony pigmentation:white Colony shape:crenate Texture:woolly Elevation:flate |
IP-6 Colony pigmentation:bluish green Colony shape:entire edge Texture:spongy. Elevation:growth into medium |
|
||
IP-7 Colony pigmentation:reddish yellow Colony shape:undulate, Texture:woolly, Elevation:flate |
Fig. 1: Morphological characteristics of endophytic fungi from A. annua
Table 1: The result of antimicrobial assay of endophytic fungi isolated from A. annua
Code of fungi |
Zone of inhibition diameter (mm) |
||||||
CA |
MF |
SM |
ST |
BS |
EC |
SA |
|
IP-1 |
NA |
NA |
6.19±0.34 |
4.38±0.33 |
5.07±0.60 |
5.27±0.60 |
4.91±0.46 |
IP-2 |
NA |
NA |
8.31±0.78 |
5.46±0.51 |
5.18±0.29 |
3.38±0.09 |
6.98±0.29 |
IP-3 |
NA |
5.43±0.40 |
NA |
NA |
NA |
4.57±0.26 |
4.92±0.36 |
IP-4 |
NA |
NA |
5.41±0.24 |
4.57±0.40 |
7.22±0.33 |
6.22±0.44 |
8.56±0.80 |
IP-5 |
NA |
NA |
NA |
NA |
NA |
3.57±0.34 |
5.19±0.58 |
IP-6 |
NA |
4.85±0.81 |
NA |
3.07±0.72 |
NA |
NA |
4.63±0.39 |
IP-7 |
NA |
4.31±0.91 |
5.46±0.35 |
4.46±0.35 |
NA |
NA |
NA |
KTZ AMX |
22.71±1.35 ND |
15.74±0.29 ND |
ND ND |
ND ND |
ND ND |
ND 21.06±1.19 |
ND 25.24±0.69 |
Values are mean±SD of triplicate observations. Diameter of zone of inhibition (mm) is not including the disc diameter of 6 mm. NA: not active, ND: not determined, CA: Candida albicans, MF: Malassezia furfur, ST: Salmonella typhi, SM: Streptococcus mutans, BS: Bacillus subtilis, EC: Escherichia coli, SA: Staphylococcus aureus, KTZ: ketoconazole, AMX: amoxycilline
 |
 |
Fig. 2: Microscopic images of fungi encode IP-4
Table 2: TLC profile of antibacterial compounds of Cladosporium sp. [23]
Compound |
Rf value |
UV 366 |
Dimethyl cladosporine |
0.37 |
Light blue |
Diacethylcladosporine |
0.53 |
Dark blue |
Cladosporine |
0.55 |
Light blue |
Metyhlcladosporine |
0.80 |
Light blue |
Characteristics of active compound were observed as the presence of color change after spraying with Dragendorff, FeCl3, acidified anisaldehyde and DNPH reagents. Dragendorff is used to identify alkaloid and N-heterocyclic compounds, which will change the color into red-orange after spraying. FeCl3 will give black color to blue if it reacts with phenolic compounds. Acidified anisaldehyde and DNPH are reagents to visualize terpenoid and ketone/aldehyde compounds respectively. The active compound gave negative results on all spray reagents used. Dimethyl cladosporine does not have any functional groups, which can be detected by using spray reagents above.

Fig. 4: TLC profile and the result of bioautography of IP-4 extract. TLC was done using plate silica gel F254 plate as stationary phase and toluene: ethyl acetate: formic acid (6:3:1 v/v/v) as mobile solvent system
UV366 nm light was used for visualization
CONCLUSION
Endophytic fungi were isolated successfully from the leaves of A. annua that has antibacterial and antifungal activity. From seven endophytic fungi obtained, fungi encoded IP-4 had the greatest activity. It was classified into Cladosporium sp. By using a bioautography method, the active compound was assumed as dimethyl cladosporine.
ACKNOWLEDGMENT
The Authors gratefully acknowledge the support of Faculty of Pharmacy Gadjah Mada University for funding this research through Research Grant Program year 2010/2011. We also thank to Diah Kurnia Sari and Fitria Setyoningrum for support in microbiological technique.
CONFLICTS OF INTERESTS
All Authors have none to declare.
REFERENCES
- WHO. World Health Statistic. Geneva; 2009.
- Hundley NJ. Structure elucidation of bioactive compounds isolated from endophytes of Alstoniascholaris and Acmenagraveolens. Thesis, Brigham Young University; 2005.
- Tan RX, Zou WX. Endophytes: a rich source of functional metabolites. Nat Prod Rep 2001;18:448-59.
- Radji M. The role of biotechnology and microbial endophyte in the development of herbal medicine. PSR 2005;2:113-26.
- Strobel G, Daisy B, Castillo U, Harper J. Natural products from endophytic microorganisms. J Nat Prod 2004;67:257-68.
- Strobel G, Daisy B. Bioprospecting for microbial endophytes and their natural products. Microbiol Mol Biol Rev 2003;67:491-502.
- Suffness M, Wall ME. Discovery and development of Taxol. In: Suffness M. Ed. Taxol® science and applications. CRC Press: Boca Raton; 1995. p. 3–25.
- Dreyfuss MM, Chapela IH. The discovery of natural products with therapeutic potential. Butterworth-Heinemann, Boston; 1994. p. 49-79.
- Miller RV, Miller CM, Garton-Kinney D, Redgrave B, Sears J, Condron M, et al. Ecomycins, unique antimycotics from Pseudomonas viridiflava. J Appl Microbiol 1998;84:937-44.
- Harrison L, Teplow D, Rinaldi M, Strobel GA. Pseudomycins, a family of novel peptides from Pseudomonas syringae, possessing broad spectrum antifungal activity. J Gen Microbiol 1998;137:2857-65.
- Castillo UJ, Harper K, Strobel GA, Sears J, Alesi K, Ford E, et al. Kakadumycins, novel antibiotics from Streptomyces sp. NRRL 30566, an endophyte of Grevilleapteridifolia. FEMS Lett 2003;24:183-90.
- Castillo UF, Strobel GA, Ford EJ, Hess WM, Poter H, Jenson JB. et al. Munumbicins, wide spectrum antibiotics produced by Streptomyces NRRL 30562, endophytic on Kennedia nisgricans. Microbiol 2002;148:2675-85.
- Verdian-rizi MR, Sadat-Ebrahimi E, Hadjiakhoondi A, Fazeli MR, Hamedani M, Pirali. Chemical composition and antimicrobial activity of Artemisia annua, L. essential oil from Iran. Pharmacogn Res 2009;1 Suppl 1:21-4.
- Bhakuni RS, Jain DC, Sharma RP, Kumar S. Review article: secondary metabolites of Artemisia annua and their biological activity. Curr Sci 2001;80:35-48.
- Anonymous. WHO Monograph on Good Agricultural and Collection Practices (GACP) for Artemisia annua L. New York; 2006. p. 7-10.
- Wright CW. Artemisia. Taylor and Francis Inc. New York; 2002.
- Potawale SE, Waseem Md, Sadiq Md, Mehta UK, Dhalawat HJ, Luniya KP, Mantri RA, et al. Research and medicinal potential of Artemisia annua:a review. Pharmacologyonline 2008;2:220-35.
- Pratiwi ST. Pharmaceutical microbiology. Erlangga Press. Jakarta; 2008.
- Ellis D, Davis S, Alexiou H, Handke R, Bartley R. Description of medical fungi. Nexus Print Solution. Adelaide; 2007.
- Guo L, Hyde K, Liew E. A method to promote sporulation in palm endophytic fungi. Fungal Divers 1998;1:109–13.
- Lacap DC, Hyde K, Liew ECY. An evaluation of the fungal “morphotype” concepts based on ribosomal DNA sequence. Fungal Divers 2003;12:53–66.
- Scott PM, Walbeek WV, Maclean WM. Cladosporin, a new antifungal metabolite from Cladosporium cladosporioides. J Antibiot 1971;24:747-55.
- Wagman GH, Weinstein MJ. Chromatography of antibiotics. 2nd Completely Revised Edition, Elsevier Science Pub. Company Inc., New York; 1984.